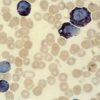

1-Acetyl-4-(4-hydroxyphenyl)piperazine, 98% 25g Acros
0 ₫
1-Acetyl-4-(4-hydroxyphenyl)piperazine, 98% 25g Acros. Code: 100340250. CAS: 67914-60-7. 1-Acetyl-4-(4-hydroxyphenyl)piperazine là chất rắn màu be. Được sử dụng trong phân tích. Quy cách đóng gói: Chai 25g
| Tên sản phẩm: | 1-Acetyl-4-(4-hydroxyphenyl)piperazine, 98% 25g Acros |
| Tên gọi khác: | 1-acetyl-4-4-hydroxyphenyl piperazine, 4-1-acetylpiperazin-4-yl phenol, 1-4-4-hydroxyphenyl piperazin-1-yl ethanone, n-acetyl-4-4-hydroxyphenyl piperazine, 4-4-acetyl-1-piperazinyl phenol,piperazine, 1-acetyl-4-4-hydroxyphenyl, 4-4-acetylpiperazin-4-yl phenol, 1-4-4-hydroxyphenyl piperazin-1-yl ethan-1-one, 1-acetyl-4-4-hydroxylphenyl piperazine |
| Code: | 100340250 |
| CAS: | 67914-60-7 |
| Công thức hóa học: | C12H16N2O2 |
| Hãng – Xuất xứ: | Acros – Mỹ |
| Ứng dụng: |
– Được sử dụng trong phân tích. |
| Tính chất: |
– Trạng thái: Dạng rắn – Màu sắc: màu be – Khối lượng mol: 220.27 g/mol – Điểm nóng chảy: 180.0°C – 185.0°C – Độ tan trong nước: 4.3g/L (20°C) |
| Thành phần: |
– Độ tinh khiết: 98% |
| Bảo quản: | – Bảo quản ở nơi khô ráo thoáng mát |
| Quy cách đóng gói: | – Chai 25g |
Sản phẩm tham khảo:
| Code | Quy cách |
| 100340250 | Chai 25g |
| 100340500 | Chai 50g |
Hãy là người đầu tiên nhận xét “1-Acetyl-4-(4-hydroxyphenyl)piperazine, 98% 25g Acros” Hủy
Sản phẩm tương tự
Hóa chất thí nghiệm
Hóa chất thí nghiệm
CAL Check™ chuẩn Clo thang cao, 0.00 và 4.00 mg/L HI96734-11 Hanna
Hóa chất thí nghiệm
Hóa chất thí nghiệm
CAL Check™ chuẩn Sắt thang cao, 0.00 và 1.50 mg/L HI96721-11 Hanna
Hóa chất thí nghiệm
Titriplex® III solution for 1000 ml, c(Na₂-EDTA 2 H₂O) = 0.01 mol/l Titrisol®
Hóa chất thí nghiệm
Potassium iodate solution for 1000 ml, c(KIO₃) = 1/₆₀ mol/l (0.1 N) Titrisol®
Hóa chất thí nghiệm
CAL Check™ Chuẩn Amoni Thang Cao, 0.0 và 25.0 mg/L HI96733-11 Hanna

Đánh giá
Chưa có đánh giá nào.